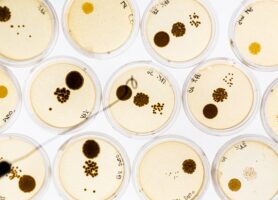
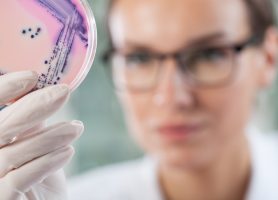

16-07-2024
#FEMSmicroBlog: Lactate metabolism as an infection route for pathogensNews
12-03-2024
We Are Hiring13-02-2024
#FEMSmicroBlog: Microbiology going comic17-09-2023
And The Winners of #MicrobeArt2023 Are...01-08-2023
EAM Hosted Two Symposia At FEMS202325-07-2023
FEMS2023: What A Congress!12-07-2023
FEMS-Jensen Awardee 2023: Rosana Alves13-06-2023
microLife in PubMedCentral31-05-2023
FEMS Journals Move to Open Access09-05-2023
We Are Hiring: Events Officer01-05-2023
In Memoriam Enrico Cabib28-03-2023
Early Bird Deadlines Close In A Few Days!22-03-2023
#MeetTheIndustry: scientifyRESEARCH20-03-2023
Find A Huge Range Of Expertise At FEMS202320-02-2023
Registration for FEMS2023 is Now Open!06-02-2023
#MeetTheIndustry: NAICONS16-01-2023
FEMS2023 is Ethical Medtech Compliant25-12-2022
Happy Holidays from the EAM05-12-2022
Out Now: Anaerobic Biological Dehalogenation10-11-2022
EAM at FEMS202331-10-2022
In memoriam Giancarlo Lancini19-10-2022
In memoriam César Nombela (1946-2022)18-10-2022
In memoriam César Nombela29-09-2022
FEMS introduces two new awards19-09-2022
FEMS Council 2022 in Trogir (Croatia)18-09-2022
And The Winners of #MicrobeArt2022 Are...15-09-2022
Short story: Mutiny12-09-2022
Short story: Constantine08-09-2022
Short story: The Sole Survivor05-09-2022
Short story: A Culture of Hope01-09-2022
Short story: A Second Hope29-08-2022
Short story: The Phage of Heroes25-08-2022
Short story: Municipal Fungal Engineer22-08-2022
Short story: Green18-08-2022
Short story: The Moralbiont15-08-2022
Short story: Not I, But We05-08-2022
In memoriam Josep Casadesús03-08-2022
#FEMSmicroBlog: Finding new polar microbes19-04-2022
Announcing the new EAM Executive Board14-03-2022
Deadline extended: FEMS-Lwoff Award04-03-2022
Statement on the Invasion of Ukraine14-02-2022
Volunteer: Join the #OnThisDay Team!14-01-2022
FEMS at DMS Congress and MiFFI Conference12-01-2022
ASM-FEMS Mäkelä Cassell Travel Award29-12-2021
Microbe of the Year goes international!20-12-2021
Science Communication projects we love07-12-2021
We present you with the EAM Members Book!02-12-2021
FEMS is seeking new Directors13-10-2021
#FEMSmicroBlog: Why Quarantining?04-10-2021
Out Now: Educating in a Pandemic and Beyond29-09-2021
Follow microLife on Twitter20-09-2021
And The Winners of #MicrobeArt2021 Are...25-08-2021
World Microbe Forum awarded18-08-2021
International Microorganism Day 202116-08-2021
#FEMSmicroBlog: What's in your kombucha?05-08-2021
Out Now: Thematic Issue on Spirit of Yeast05-07-2021
In memoriam Hans-Dieter Klenk (1938-2021)28-06-2021
Get ready for Belgrade!24-06-2021
Excellent iPosters awarded24-06-2021
And the winner is...10-06-2021
Out Now: Thematic Issue on C1 Metabolism08-06-2021
New EAM Member: Prof. Tobias Erb31-05-2021
FEMS Yeast Research Webinar on Yeast Lipids05-05-2021
Register Now for the World Microbe Forum!03-05-2021
Welcome to our new podcast Microbes and Us!21-04-2021
Early-Bird Registration Opens Today29-03-2021
Second chance to submit an abstract!24-03-2021
#FEMSmicroBlog: World Tuberculosis Day 202108-03-2021
International Women's Day Live Stream08-03-2021
Perspectives: Drowning in a Sea of Silence24-02-2021
#FEMSmicroBlog: Our first microbes15-02-2021
Big Thank You To Our Reviewers!11-02-2021
Meet the Programme Committee Chairs13-01-2021
Out Now: Thematic Issue on Yeast Genomes12-01-2021
FEMS introduces 2 new awards12-01-2021
Abstract Submissions Are Now Open05-01-2021
Welcome, Kosovo Society for Microbiology30-12-2020
#FEMSmicroBlog: Microbe Media21-12-2020
FEMS and ASM announce World Microbe Forum17-12-2020
#FEMSmicroBlog: Some microbes like it hot!24-11-2020
World Antimicrobial Awareness Week 202017-11-2020
Join the FEMS Grants Committee16-11-2020
#FEMSmicroBlog: Receptors of coronaviruses26-10-2020
In memoriam Lars Bogø Jensen (1961-2020)17-09-2020
And The Winners of #MicrobeArt2020 Are...11-09-2020
International Microorganism Day 202002-09-2020
Out Now: Three New Thematic Issues19-08-2020
New EAM Member: Prof. Iñigo Lasa Uzcudun29-07-2020
FEMS2021 goes online16-07-2020
New EAM Member: Prof. Mariana Pinho09-07-2020
The first Editorial from microLife22-06-2020
Behind the scenes at FEMS22-06-2020
NEW: Online Meeting Organizer Grants (MOG)17-06-2020
New EAM Member: Prof. Josep Casadesús16-06-2020
FEMS Yeast Research: 20th Anniversary08-06-2020
Out Now: Sponge Microbiome02-06-2020
Connecting People. Sharing Knowledge.19-05-2020
#FEMSmicroBlog: Sex in industrial yeasts19-05-2020
New EAM Member: Prof. Thomas Nyström17-04-2020
New EAM Member: Prof. Paul Rainey01-04-2020
Out Now: Education, Wherever We Are20-03-2020
עדכון מומחים- נגיף הקורונה20-03-2020
New EAM Member: Prof. Isabel Gordo13-03-2020
FEMS response to COVID-1902-03-2020
FEMS-ESCMID Award28-02-2020
Read and Publish: Fee-free OA publication?13-02-2020
New EAM Member: Prof. Sigal Ben-Yehuda04-02-2020
Expert statement on coronavirus (COVID-19)09-01-2020
In memoriam Milton S da Costa (1948-2020)08-01-2020
Out Now: Yeast Ecology and Interactions31-12-2019
Building Impact: Brick by Brick30-12-2019
Brick #4: the difference a lab can make29-12-2019
Brick #3: blogging about the little world...23-12-2019
Happy 2020!12-12-2019
Out Now: Applications of Mathematical Models10-12-2019
Out Now: Thematic Issue on Ecology of Soils10-12-2019
Meet Ally Hughes, PhD Student04-12-2019
Meet Sophie Howard, PhD Student12-11-2019
Poster Networking Sessions at FEMS201922-10-2019
Dr Sarah Zecchin, FEMS-Jensen Awardee08-10-2019
FEMS Annual Report 2018 Published07-10-2019
We Are Recruiting New Directors30-09-2019
The FEMS Brand – a logo (r)evolution27-09-2019
The FEMS Summer School for Postdocs24-09-2019
And The Winners of #MicrobeArt2019 Are...30-08-2019
FEMS Journal Poster Prize Winners21-08-2019
FEMS2019 Photo Album01-08-2019
Out Now: Thematic Issue on CRISPR-Cas19-07-2019
What a congress!16-04-2019
What is the FUNBREW Project?27-03-2019
Winner of the FEMS-ESCMID Award announced!11-03-2019
In memoriam Fergus (Gus) Priest (1948-2019)06-03-2019
In memoriam Agnès Ullmann (1927-2019)15-02-2019
New FEMS policies in place30-01-2019
Spotlight on… Regine Hengge12-12-2018
Out Now: Industrial Microbiology27-11-2018
A Tribute to Professor Riks Laanbroek08-11-2018
Meet Editor-in-Chief: Rich Boden26-10-2018
Out Now: Subsurface Microbiology24-09-2018
Get Ready for the #EUROmicroMOOC!13-08-2018
Meet FEMS Expert: Chantal Abergel11-08-2018
Journal poster prizes – investing in science18-07-2018
Meet our new volunteer teams16-07-2018
Meet FEMS Expert: Tam Mignot12-07-2018
FEMS 2019 Confirmed speakers18-06-2018
Meet FEMS Expert: Ulrich Dobrindt06-06-2018
Joint Special Issue with Member Societies29-05-2018
Out now: Climate Change Thematic Issue24-05-2018
Diversity in Peer Review21-05-2018
Meet FEMS Expert: Petra Dersch08-05-2018
Meet Editor-in-Chief: Max Häggblom25-04-2018
Meet FEMS Expert: Uri Gophna23-04-2018
Meet FEMS Taskforce Lead: Tina Silovic17-04-2018
Meet the new FEMS Grants Committee12-04-2018
FEMS Journals Grants: Investing in science12-04-2018
Toby Kiers - Keynote speaker for FEMS 201910-04-2018
Meet FEMS Delegate: Katrine Uhrbrand24-03-2018
Tuberculosis: a new old problem05-03-2018
Meet FEMS Expert: Dr Philippe Glaser28-02-2018
Welcoming new FEMS Experts12-02-2018
New and simplified Opportunities form!30-01-2018
Out now: Six Key Topics in Microbiology 201823-01-2018
My microbiology hero - Lwoff22-01-2018
Post your opportunity15-01-2018
Introducing new editor: Justin Nodwell21-12-2017
Looking back at a fantastic 201711-12-2017
Cletus P. Kurtzman 1938-201709-11-2017
Out now: Chlamydia Thematic Issue08-11-2017
Meet Editor-in-Chief: Jens Nielsen03-11-2017
One Health Day with Prof Richard Kock30-10-2017
Out now: Yeast Cell Factories Thematic Issue24-10-2017
Introducing new editor: Christian Münz16-10-2017
World Food Day with Dr Irene Hoffman, FAO04-10-2017
New Directors04-10-2017
Lithuania newest member of the ‘FEMS Family’26-09-2017
Out now: Neisseria Thematic Issue04-09-2017
Out now: Pseudomonas thematic issue22-08-2017
Out now: Lactic Acid Bacteria supplement18-08-2017
Out now: Vaccines virtual special issue11-08-2017
Winners of the Engage your Audience! contest03-08-2017
Thank you for completing our survey!21-07-2017
Testimonials from FEMS 201710-07-2017
One Health: Understanding AMR05-07-2017
Share your experiences in our survey05-07-2017
Out now: Congress Special newsletter22-06-2017
Out now: One Health Thematic Issue22-06-2017
One Health Policy: Where are we?21-06-2017
Out now: new special issue on E. coli19-06-2017
Discovering new antibiotics16-06-2017
Out now: Virtual Special Issue for ISSY3313-06-2017
Meet FEMS Expert: Dr Ramon Rossello-Mora29-05-2017
Meet FEMS Expert: Professor Urs Jenal15-05-2017
One Health: What is it?05-05-2017
In memoriam: Dieter Haas02-05-2017
New statutes for FEMS28-04-2017
Spotlight on… SEM Jaime Ferran Awardee26-04-2017
Spotlight on… our FEMS-ESCMID Awardee25-04-2017
Meet FEMS Expert: Professor Oscar Kuipers13-04-2017
Winner of FEMS-ESCMID Award announced!04-04-2017
Winner of FEMS-Lwoff Award announced!29-03-2017
Out now: Sulfur Metabolism Thematic Issue18-03-2017
Meet FEMS Expert Professor Victor de Lorenzo10-03-2017
FEMS Microbiology Letters turns 40!08-03-2017
International Women's Day - 8 March 201728-02-2017
EU Health Award prize winners: WAAAR07-02-2017
And the winner is…20-01-2017
ERC Synergy Grants 201816-01-2017
Zika virus: a New Year update18-11-2016
AMR at FEMS 201717-11-2016
Hot topic: Sow antibiotics, reap trouble08-11-2016
In Memoriam Godfried D. Vogels27-10-2016
Hot topic: the seaweed holobiont20-10-2016
Hot topic: A new hope for salami production17-10-2016
Register now for FEMS 201710-10-2016
Hot topic: Send them to outer space07-10-2016
Retrospective: Andriy Sibirny26-09-2016
FEMS is looking for a Communications Officer22-09-2016
A private affair22-09-2016
Peer Review Week is here!20-07-2016
A century-old technology still developing01-07-2016
Funding network27-06-2016
Biography Antoni van Leeuwenhoek13-06-2016
Hot topic: CRISPR11-05-2016
Interview with Patrice Courvalin, M.D.